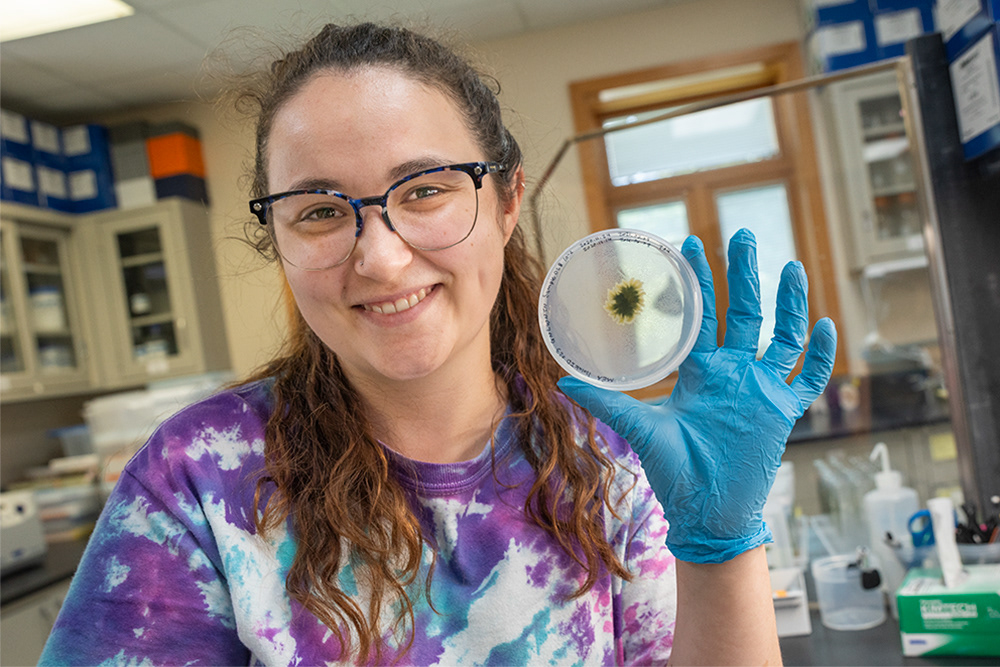
Holden Forests and Gardens Science Research Student

Artist Leigh Brooklyn

Russ Mitchell, 3News Anchor

Devo cofounder Mark Mothersbaugh

Philippe Cousteau Jr., American oceanographer and environmental activist

Artist, Jordan Wong

Caroline Tait, Vice President of Horticulture and Collections at Holden Forests and Gardens

Artist Alyssa Lizzini

Artist, Robert Wyland

Mike Polk Jr.

Chef Doug Katz

Juan Vergara of Barroco Grill

Dr. Charles Modlin, M.D., MBA

Artist Derek Brennan

Family Portraits

Cara Lageson

Native American Chief Wahoo Protester

Native American Chief Wahoo Protester

Cindy Barber of The Beachland Ballroom Tavern

MOCA Cleveland's summer 2017 exhibition - Constant as the Sun

Family Portraits

Sprenger Health Care Amherst Manor Retirement Community

Courtney Mintz

Father Begin, St. Colemans

Fran DiDonato

Artist, Gadi Zamir

Bella Sin of Cleveland Burlesque / Ohio Burlesque

Artist, Liz Maugns

Jackie Meger

Jacqueline Bon

Margaret Thresher

Katie Morris

Sprenger Health Care Amherst Manor Retirement Community

Harriett Logan of Loganberry Books

Mansfield Frazier - the Vineyards of Château Hough

MetroHealth Board Members

Artist, Keith Mayerson

Bill "Mr. Stress" Miller

Grant Smrekar of Rust Belt Welding

Marisa Sergi founder of Red Head Wine

Sara Denunzio

Artist, Sequoia Bostick

Tobey Anne Russell at the Garfield Bldg Downtown Cleveland

Artist, Virgie Patton

Journalist, Mark Oprea

Ohio City Farm Worker

Raven and his dog, Nanuke

Sergio Abramof, owner of Sergio's Restaurant

Author, Dan Chaon

American jazz trumpeter, Kamal Abdul Alim

Holden Forests and Gardens Science Research Student

Amelea Zamir

Shamus Dickinson

Sommer Tolan, Horticulturist at Holden Forests and Gardens

D-Day Reinactor

Photographer Da’Shaunae Marisa and models

Dee Jay Doc

Chef Zack Bruell

Family Portraits

Family Portraits

Michelle Leyden Nguyen